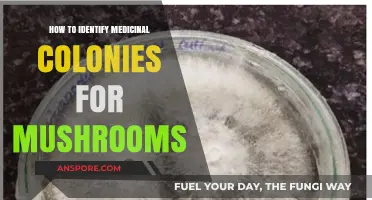
Identifying Medicinal Mushroom Colonies: A Comprehensive Guide for Foragers

Mushrooms are often recognized as the visible, above-ground structures of fungi, but they are not the organism itself—rather, they are the fruiting bodies produced by certain types of fungi. These fruiting bodies serve as reproductive organs, releasing spores to propagate the fungus. While the mushroom is the most familiar part of the fungus, it is just one stage in the life cycle of these organisms, which primarily exist as a network of thread-like structures called mycelium beneath the surface. Understanding that mushrooms are fruiting bodies highlights their role in fungal reproduction and their transient nature in the broader fungal ecosystem.
| Characteristics | Values |
|---|---|
| Definition | A mushroom is the fleshy, spore-bearing fruiting body of a fungus, typically produced above ground on soil or its food source. |
| Fungal Structure | Mushrooms are part of the fruiting body of fungi, which also includes other structures like spores, mycelium, and sometimes rhizomorphs. |
| Purpose | The primary purpose of a mushroom is to produce and disperse spores, ensuring the fungus's reproduction and survival. |
| Visibility | Mushrooms are the visible, above-ground part of the fungus, while the mycelium (the vegetative part) remains hidden beneath the surface. |
| Lifespan | Mushrooms are ephemeral, often lasting only a few days to weeks, depending on environmental conditions and species. |
| Composition | Consists of a cap (pileus), gills or pores (hymenium), and a stem (stipe), all of which are involved in spore production and dispersal. |
| Ecological Role | Mushrooms play a crucial role in ecosystems by decomposing organic matter, recycling nutrients, and forming symbiotic relationships with plants. |
| Edibility | Some mushrooms are edible and highly prized in culinary traditions, while others are toxic or hallucinogenic, requiring careful identification. |
| Diversity | There are over 14,000 known mushroom species, with many more yet to be discovered, showcasing immense biodiversity in fungi. |
| Growth Conditions | Mushrooms typically grow in damp, dark environments with organic matter, such as forests, fields, and decaying wood. |
Explore related products
What You'll Learn
- Mushroom Structure Basics: Mushrooms consist of a cap, stem, gills, and mycelium network underground
- Fruiting Body Definition: Fruiting bodies are reproductive structures produced by fungi to disperse spores
- Mushroom vs. Mycelium: Mushrooms are visible fruiting bodies; mycelium is the hidden, nutrient-absorbing network
- Spores and Reproduction: Mushrooms release spores from gills or pores to propagate the fungus
- Edible vs. Non-Edible: Not all fruiting bodies are mushrooms, and not all mushrooms are safe to eat

Mushroom Structure Basics: Mushrooms consist of a cap, stem, gills, and mycelium network underground
Mushrooms, often recognized by their distinctive cap and stem, are indeed the fruiting bodies of a much larger organism known as the mycelium. The mycelium is a network of thread-like structures called hyphae that grow underground or within decaying matter, absorbing nutrients and supporting the mushroom's life cycle. The mushroom itself, which emerges above ground, serves primarily as a reproductive structure, releasing spores to propagate the species. Understanding the basic structure of a mushroom—its cap, stem, gills, and the underlying mycelium—provides insight into its function as a fruiting body.
The cap is perhaps the most recognizable part of a mushroom, often colorful and variably shaped. It acts as a protective covering for the gills or pores underneath, which are crucial for spore production. The cap's size, shape, and color can vary widely among species, aiding in identification. Beneath the cap lies the stem, which supports the cap and elevates it to facilitate spore dispersal. The stem's length, thickness, and texture are additional characteristics used in mushroom classification. Together, the cap and stem form the above-ground structure that we commonly refer to as a mushroom.
Attached to the underside of the cap are the gills, which are thin, blade-like structures where spores are produced. In some mushroom species, pores or spines replace gills, serving the same purpose. As the mushroom matures, the gills release vast quantities of spores into the environment. These spores are analogous to plant seeds, capable of growing into new mycelium networks under suitable conditions. The gills' arrangement, color, and attachment to the stem are key features for identifying mushroom species.
Beneath the surface, the mycelium network is the mushroom's vegetative part, responsible for nutrient absorption and growth. This extensive network of hyphae can span large areas, breaking down organic matter and recycling nutrients in ecosystems. The mycelium remains hidden, sustaining the organism until conditions are right for the mushroom fruiting body to emerge. This underground network highlights the mushroom's role as a fruiting body—a temporary structure produced by the mycelium for reproduction.
In summary, a mushroom's structure—comprising the cap, stem, gills, and mycelium—underscores its function as a fruiting body. While the cap, stem, and gills are visible and aid in reproduction, the mycelium operates unseen, sustaining the organism. This dual structure exemplifies the mushroom's unique biology, where the fruiting body is just one phase in the life cycle of the larger mycelium network. Understanding these basics is essential for appreciating mushrooms' ecological roles and their significance as fruiting bodies.
Mushroom Microdosing: Finding Your Ideal Milligram Range
You may want to see also

Fruiting Body Definition: Fruiting bodies are reproductive structures produced by fungi to disperse spores
Fruiting bodies are essential reproductive structures in the life cycle of fungi, serving the primary purpose of producing and dispersing spores. These structures are the visible parts of fungi that emerge from the underlying mycelium, the network of thread-like filaments that form the fungus's vegetative body. The mycelium remains hidden, often beneath the soil or within organic matter, while the fruiting body develops above ground or in exposed areas to facilitate spore dispersal. This distinction is crucial in understanding the role of fruiting bodies, as they are not the entirety of the fungus but rather specialized organs for reproduction.
In the context of mushrooms, the answer to the question "Is a mushroom a fruiting body?" is yes. Mushrooms are indeed fruiting bodies of certain types of fungi, particularly those belonging to the Basidiomycota and Ascomycota divisions. When we see a mushroom, we are observing the mature fruiting body that has developed to release spores into the environment. The mushroom's cap, gills, and stem are all parts of this reproductive structure, designed to maximize spore production and dispersal. The gills, for instance, are lined with basidia (spore-bearing cells) in basidiomycetes, which release spores that can be carried away by air currents, animals, or water.
The development of fruiting bodies is a complex process triggered by environmental cues such as changes in temperature, humidity, and nutrient availability. For example, many fungi produce fruiting bodies in response to cooler temperatures and increased moisture, conditions that often signal the transition from vegetative growth to reproductive phase. Once formed, the fruiting body's primary function is to ensure the survival and spread of the fungus by releasing spores, which can travel to new locations and germinate under favorable conditions to form new mycelia.
Fruiting bodies exhibit a wide range of shapes, sizes, and colors, reflecting the diversity of fungal species. While mushrooms are among the most recognizable, other types of fruiting bodies include puffballs, truffles, and bracket fungi. Each of these structures is adapted to its specific environment and method of spore dispersal. For example, puffballs release spores through a small opening when disturbed, while truffles rely on animals to dig them up and disperse their spores. This diversity highlights the evolutionary success of fungi in utilizing fruiting bodies as a reproductive strategy.
Understanding the definition and function of fruiting bodies is key to appreciating the role of fungi in ecosystems. Fungi are decomposers, breaking down organic matter and recycling nutrients, and their fruiting bodies play a vital role in this process by ensuring the continuation of fungal populations. Moreover, many fruiting bodies, including mushrooms, are edible and have been utilized by humans for food and medicine for centuries. However, it is important to note that not all fruiting bodies are safe to consume, and proper identification is essential to avoid toxic species. In summary, fruiting bodies are not only fascinating biological structures but also critical components of fungal biology and ecology.
Mushroom Burger: A Meatless Marvel
You may want to see also

Mushroom vs. Mycelium: Mushrooms are visible fruiting bodies; mycelium is the hidden, nutrient-absorbing network
When exploring the question "is a mushroom a fruiting body," it becomes clear that mushrooms are indeed the visible, above-ground structures produced by certain fungi. These fruiting bodies serve primarily for reproduction, releasing spores into the environment to propagate the species. However, the mushroom itself is only a small part of the larger fungal organism. Beneath the surface lies the mycelium, a vast, hidden network of thread-like structures called hyphae. This distinction between mushroom vs. mycelium is fundamental to understanding fungal biology. While the mushroom is the reproductive organ, the mycelium is the vegetative body responsible for nutrient absorption, growth, and survival.
The mycelium operates as the fungus's primary nutrient-absorbing network, secreting enzymes to break down organic matter and absorb essential nutrients from its surroundings. This hidden system can span vast areas, often remaining unnoticed despite its critical role in ecosystems. For example, a single mycelial network can interconnect multiple plants, facilitating nutrient exchange and communication in what is known as the "wood wide web." In contrast, mushrooms emerge only under specific conditions, such as adequate moisture and temperature, to fulfill their reproductive purpose. This ephemeral nature of mushrooms highlights their secondary role compared to the persistent, life-sustaining mycelium.
From a practical perspective, the mushroom vs. mycelium comparison is crucial in fields like agriculture, medicine, and ecology. Mushrooms are harvested for food, medicine, and research due to their accessibility and concentrated bioactive compounds. Mycelium, on the other hand, is increasingly valued for its potential in bioremediation, packaging materials, and as a sustainable alternative to animal leather. Understanding the distinct functions of these two components allows for targeted applications, such as cultivating mushrooms for culinary use while harnessing mycelium for environmental restoration.
In the context of fungal life cycles, mushrooms represent the culmination of mycelial growth under favorable conditions. They are the means by which fungi disperse genetically diverse spores, ensuring survival across generations. Meanwhile, the mycelium persists as the foundation of the organism, continuously expanding and adapting to its environment. This symbiotic relationship between the visible fruiting body and the hidden network underscores the complexity and efficiency of fungal life strategies.
Finally, appreciating the difference between mushroom vs. mycelium enhances our respect for fungi's ecological significance. Mushrooms may capture our attention with their diverse shapes and colors, but it is the mycelium that drives nutrient cycling, soil health, and ecosystem resilience. By recognizing mushrooms as fruiting bodies and mycelium as the nutrient-absorbing network, we gain a holistic view of fungi's dual nature—one part visible and reproductive, the other hidden and life-sustaining. This knowledge not only answers the question "is a mushroom a fruiting body" but also deepens our understanding of fungi's indispensable role in the natural world.
Did Massachusetts Voters Approve the Mushroom Initiative on the Ballot?
You may want to see also
Explore related products

Spores and Reproduction: Mushrooms release spores from gills or pores to propagate the fungus
Mushrooms are indeed the fruiting bodies of fungi, and their primary role is to facilitate reproduction. Unlike plants, which use seeds for propagation, fungi rely on spores—microscopic, single-celled structures—to disperse and colonize new environments. The mushroom itself is a temporary structure that emerges from the underlying network of fungal threads called mycelium. Its sole purpose is to produce and release spores, ensuring the survival and spread of the fungus. This reproductive strategy is both efficient and adaptable, allowing fungi to thrive in diverse ecosystems.
The spores of mushrooms are typically released from specialized structures located on the underside of the cap. In many mushroom species, these structures are gills—thin, radiating plates that provide a large surface area for spore production. Each gill is lined with spore-bearing cells called basidia, which produce and release spores into the air. When mature, the spores are discharged in a process often aided by environmental factors such as air currents or water droplets. This dispersal mechanism increases the likelihood of spores reaching new habitats where they can germinate and grow.
In other mushroom species, spores are released from pores instead of gills. These pores are small openings found on the underside of the cap, often arranged in a honeycomb-like pattern. The spores develop within the pores and are eventually released through them. This method, while different from the gill system, serves the same purpose: to propagate the fungus by dispersing spores over a wide area. Both gills and pores are highly efficient structures, maximizing spore production and release to ensure successful reproduction.
The process of spore release is a critical phase in the fungal life cycle. Once released, spores can travel great distances, carried by wind, water, or even animals. When a spore lands in a suitable environment with adequate moisture, nutrients, and temperature, it germinates and grows into a new mycelium. This mycelium will eventually produce its own fruiting bodies, continuing the reproductive cycle. The ability of mushrooms to release vast numbers of spores increases the chances of successful colonization, even in challenging or unpredictable environments.
Understanding the role of spores and their release from gills or pores highlights the ingenuity of fungal reproduction. Mushrooms, as fruiting bodies, are not just peculiar organisms but essential components of the fungal life cycle. By producing and dispersing spores, they ensure the survival and proliferation of fungi, which play vital roles in ecosystems as decomposers, symbionts, and nutrient cyclers. Thus, the release of spores from gills or pores is not merely a biological process but a fundamental mechanism that sustains fungal life and contributes to the health of our planet.
Are Mushrooms Producers? Unraveling Their Role in the Food Chain
You may want to see also

Edible vs. Non-Edible: Not all fruiting bodies are mushrooms, and not all mushrooms are safe to eat
In the world of fungi, the term "mushroom" is often used colloquially to describe a wide variety of fruiting bodies, but not all fruiting bodies are mushrooms, and not all mushrooms are safe to eat. A fruiting body is the reproductive structure of a fungus, produced to disseminate spores. While mushrooms are indeed a type of fruiting body, characterized by their cap-and-stem structure, they represent only a fraction of the diverse forms that fungal fruiting bodies can take. Other types of fruiting bodies include puffballs, bracket fungi, and cup fungi, each with distinct structures and ecological roles. Understanding this distinction is crucial when foraging, as it helps in identifying whether a fruiting body is a mushroom and whether it is edible.
When it comes to edibility, the line between safe and toxic mushrooms is often thin and requires careful identification. Edible mushrooms, such as button mushrooms (*Agaricus bisporus*), shiitakes (*Lentinula edodes*), and chanterelles (*Cantharellus cibarius*), are prized for their culinary uses and nutritional benefits. However, they share morphological similarities with poisonous species like the deadly Amanita (*Amanita bisporigera*) or the destroying angel (*Amanita ocreata*). Even experienced foragers can mistake toxic species for edible ones, emphasizing the importance of proper identification. Key features to examine include the color, shape, gill structure, spore print, and habitat, as these can vary significantly between species.
Non-edible fruiting bodies, on the other hand, serve vital ecological functions but are not suitable for consumption. For example, bracket fungi, often found growing on trees, play a crucial role in decomposing wood but are typically tough and unpalatable. Similarly, puffballs, while sometimes edible when young and white inside, can become toxic or indigestible as they mature. Some fruiting bodies, like the stinkhorns (*Phallus impudicus*), are not only inedible but also emit foul odors to attract insects for spore dispersal. Recognizing these non-edible forms is as important as identifying edible mushrooms to avoid accidental ingestion.
The misconception that all mushrooms are safe to eat can have serious consequences. Toxic mushrooms contain compounds like amatoxins, orellanine, or muscarine, which can cause symptoms ranging from gastrointestinal distress to organ failure or even death. For instance, the innocuous-looking death cap (*Amanita phalloides*) is responsible for the majority of fatal mushroom poisonings worldwide. Conversely, not all non-mushroom fruiting bodies are toxic; some, like the morel (*Morchella* spp.), are highly prized edibles despite their unique, honeycomb-like appearance. This highlights the need for precise identification rather than relying on general assumptions.
In conclusion, while mushrooms are a well-known type of fruiting body, they are just one part of the fungal kingdom’s diverse reproductive structures. Distinguishing between edible and non-edible species requires knowledge, caution, and often expert guidance. Not all fruiting bodies are mushrooms, and not all mushrooms are safe to eat—a principle that underscores the importance of accurate identification in foraging. Whether for culinary exploration or ecological appreciation, understanding the differences between these fungal forms ensures both safety and respect for the natural world.
Mushroom Picking: Best Times and Seasons to Forage
You may want to see also
Frequently asked questions
Yes, a mushroom is the fruiting body of a fungus, produced to release spores for reproduction.
It means the mushroom is the visible, spore-producing structure of a fungus, analogous to the fruit of a plant.
Yes, all mushrooms are fruiting bodies, though not all fungi produce visible mushrooms as their fruiting structures.
The purpose is to disperse fungal spores into the environment, allowing the fungus to reproduce and spread.
No, the mushroom is only the reproductive part; the main body of the fungus is usually hidden underground or in decaying matter as mycelium.